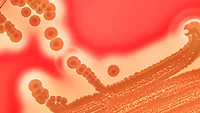
staphylococcus

Study: PCHF Compliance Costs Small and Midsized Food Businesses $22,000 in First Year Alone

Image credit: jcomp via Freepik
Implementation of food safety systems that meet the requirements of the U.S. Food and Drug Administration’s (FDA’s) Food Safety Modernization Act (FSMA) Preventive Controls for Human Food Rule (PCHF Rule) can cost small- and medium-sized businesses an average of $22,000 in the first year alone, according to new research from the University of Massachussetts Amherst (UMass Amherst).
Published in PLOS One, the study was conducted by Jill Ann Fitzsimmons, Ph.D.; Amanda J. Kinchla, M.S., and Christina Allingham, Ph.D. candidate. The researchers found that, aside from the $22,000 initial price tag of PCHF compliance, businesses can expect to shell out approximately $8,000 in every subsequent year to maintain the necessary systems.
Compliance with the PCHF Rule is mandatory for all large food companies, but for businesses qualifying as “small,” “very small,” or otherwise meeting certain sales criteria (considered midsized in the study), exemptions for compliance are available—but all businesses are still encouraged by FDA to meet full PCHF standards, and must still comply with Current Good Manufacturing Practices (GMPs) and Hazards Analysis and Critical Control points (HACCP), as well as local and state regulations. Exempt businesses may still face pressure from downstream supply chain partners to fully meet PCHF requirements for third-party certification purposes, adding motivation for small and midsized companies to fully comply with the PCHF Rule.
Although the hefty cost of planning, implementing, and managing systems in compliance with the PCHF Rule is a significant barrier for small and midsized food businesses, the study demonstrates that demystifying the cost of PCHF compliance through training interventions can reduce barriers for small and midsized businesses.
To identify the cost of PCHF compliance, the UMass researchers worked with 81 small and midsized businesses in the Northeast U.S. They were provided modified Preventive Controls Qualified Individual (PCQI) training materials—which are now offered online through the UMass Extension—that included concrete cost information. The researchers evaluated whether the modified PCQI content improved the participating businesses’ knowledge about PCHF compliance costs throughout the programming, and also measured actual costs associated with compliance activities through interviews at the end of the programming.
Overall, the study demonstrated that merely acknowledging the costs that small and midsized businesses might incur while pursuing PCHF compliance is an important step in reducing barriers to compliance. The researchers suggest that food safety educators address economic realities in training materials that are currently exclusively limited to food safety topics.
Looking for quick answers on food safety topics?
Try Ask FSM, our new smart AI search tool.
Ask FSM →